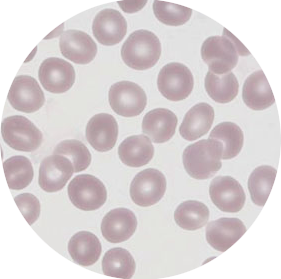

There are no items in your cart
Add More
Add More
| Item Details | Price | ||
|---|---|---|---|
In the context of the exam questions this means that: you may be asked to recall some facts, events or process in an accurate way.
eg, if you are shown this microscope picture of human blood you would be expected to recognise that it shows red blood cells. To describe the cells you would simply write what you see, they are a red colour, round in shape and have a light area in the middle showing their flattened disc like shape.
You may be asked to describe how it's a structure relates to its function, you would then need to apply your scientific knowledge and understanding, not just describe what you see. In this example you would need to mention it is used for carrying oxygen from the lungs to the tissues and that it's flattened shape gives it a large surface area for gas exchange and how the absence of a nucleus allows for larger quantities of the respiratory pigment haemoglobin to be carried.
It's important to be clear about what is meant by structure and and what is meant by function. The structure is what you see, it is something you can label on a diagram. The function is the purpose of the structure - what it does, it's job.
Describing graphs is an important topic in it's own right and has an entire lesson devoted to it.